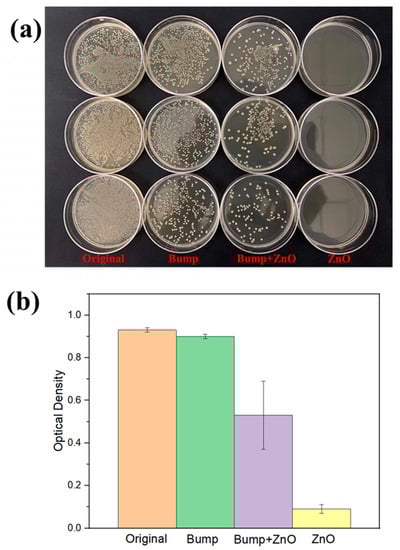

Abstract
Superhydrophobic surfaces are important in many applications owing to their special properties such as self-cleaning, anti-icing, antibacterial, and anti-fogging. In this paper, a micro/nano hierarchical superhydrophobic surface with a low roll-off angle was created on 304 stainless steel. The water contact angle was measured to be 152° with a roll-off angle of 7.3°. Firstly, microscale bumps were created by femtosecond laser irradiation. Secondly, zinc oxide (ZnO) nanowires were fabricated on the laser-induced bumps using a hydrothermal synthesis method. Results show that after laser treatment and ZnO nanostructuring, the stainless steel surface became superhydrophobic. However, the roll-off angle of this hierarchical structure surface was larger than 90°. To reduce the surface activity, trimethoxy silane hydrophobic coating was applied. A 7.3° roll-off angle was achieved on the coated surface. The underlying mechanism was discussed. The hydrophobic ZnO structured surface can help prevent bacterial contamination from water, which is important for implants. Thus, for biomedical applications, the antibacterial property of this hierarchical surface was examined. It was found that the antibacterial property of sample surfaces with ZnO nanowires were significantly increased. The optical density (OD) of Escherichia coli (E. coli) attached to the original surface was 0.93. For the micro-structured surface (with bumps), the OD was 0.9, and for the hierarchical surface (with bump & nanowires), it was 0.54. For nanostructured ZnO nanowire surface, the OD was only 0.09. It demonstrates good antibacterial properties of ZnO nanowires.
1. Introduction
Surface wettability modifications have various applications such as self-cleaning, oil-water separation, bubble manipulation, liquid directional transport, mist collection, antibacterial, self-healing, etc. The surface wettability could be well-controlled by surface structures. It was reported that with micro/nano scale structure created on material surface, the wettability can be modified to either hydrophilic or hydrophobic [1]. Recently, there has been increased research on the biomimetic surface for wettability control. A famous example is the mimetic surface of lotus leaf, which is superhydrophobic (water contact angle > 150°) with a low sliding angle (<5°). This is due to its hierarchical structure of hemispherical papillae with a size of 5–10 µm and 150 nm dentritic mastoid [2]. The water droplet can remain in a spherical shape on the surface, mingle with dust, and roll down with a cleaned surface left. The “lotus effect” is generally referring to self-cleaning surfaces [3]. Superhydrophobic surfaces are widely used in aerospace, microfluidics, biomedicines, and industries. A superhydrophobic surface can enhance surface anti-corrosion property, antibacterial property, and reduce surface adhesion and surface resistance. A superhydrophilic surface could enhance surface adhesion, improve heat transfer, and help in cell fixing. Typical superhydrophilic examples from nature include raspberry-like hierarchical structure, tillandsia usneoides (hair structure), and sphagnum moss (pore structure). Other biomimetic surfaces include rose petals [4], taro leaves [5], butterfly wings [6], and penguin body feather [7]. In this paper, microscale structures refers to structures larger than 1µm and nanoscale structures refers to structures less than 1 µm.
Compared with traditional micro-nano processing methods, such as CNC machining [8], chemical etching [9], ion beam processing [10], etc., ultrashort-pulsed laser processing has the advantages of being non-contact, simple, fast, and environmentally friendly. Ultrashort-pulsed laser with a small thermal effect can be tightly focused onto a tiny spot to create micro and/or nano structures that mimic hierarchical morphology from the natural world, such as lotus leaves and shark skin, whose surface usually exhibits extreme non-wettability [11]. Gaddam et al. applied femtosecond laser to fabricate a two-tier multiscale topography on stainless steel surface. With femtosecond laser irradiation, microscale bumps were created on the surface together with nanoscale LIPSS [12]. Wang et al. [13] reported a one-step method to fabricate micro/nano hierarchical structure on nickel surface by picosecond laser. The laser fluence was adjusted slightly above its ablation threshold, and micro-scale bumps were fabricated with nanoscale ripples (or LIPSS) formed on the surface. Žemaitis et al. [14] fabricated nanoscale ripples on stainless steel surface and examined the surface wettability at different laser processing parameters. A superhydrophobic surface was achieved. Wang et al. [15] fabricated micro-pits and micro-grooves on polystyrene surface by employing a femtosecond laser; the surface wettability was successfully modified to either highly hydrophilic or superhydrophobic. Hierarchical structures containing both micro- and nanoscale structures have advantages owing to its high durability and low sliding angle. Pan et al. [16] applied a hybrid method to fabricate a triple-scale superhydrophobic structure. The surface was highly robust. In general, laser surface texturing is either in microscale (such as micro-bumps, micro-pits & micro-grooves) or in nanoscale. It has high precision control for micro-structure fabrication, while for nanoscale structure fabrication, it mainly focuses on LIPSS fabrication, and the precision control on nanoscale structures is still difficult. Thus, usually a hybrid fabrication method is applied for hierarchical structure fabrication.
ZnO nanowires are increasingly used for surface nano-structuring and wettability control owing to its simple synthesis control [17]. In addition, it has good biocompatibility and antibacterial property, which makes it suitable for biomedical applications [18]. Mishra et al. [19] investigated the different growth direction of ZnO nanowires and found that the polar and non-polar growth direction of ZnO nanowires could directly affect the surface wetting behavior [17]. Yong et al. [20] applied femtosecond laser to create micro/nano ZnO structures on zinc metal surface. The surface wettability could be switched between hydrophobic to hydrophilic with UV light irradiation. Ghannam et al. [21] studied the wettability of ZnO nanorods grown on fluorine-doped tin oxide (FTO). It was found that the polar, non-polar facets have significant effect on surface wettability. The hydrophilic ZnO nanowire tips result in a sticky surface. Huang et al. [22] reported a ZnO superhydrophobic surface fabricated by electrophoretic deposition process on aluminium alloy substrate. The effect of deposited temperature on surface wettability was discussed. ZnO nanoparticles have been reported as a non-toxic material to the human body [23]. It has been reported that ZnO nanoparticles have good biocompatibility and antibacterial properties [24]. Abebe et al. [25] serially discussed the antibacterial property and surrounding mechanism of ZnO material. Shaban et al. [26] studied the wettability and antibacterial property of ZnO coated cotton fabric surfaces. A superhydrophobic surface was achieved with antibacterial property.
Despite the many investigations on laser metal surface mico/nano processing and ZnO surface properties, a simple and fast fabrication of hierarchical micro/nano structure with superhydrophobicity and antibacterial property by femtosecond laser irradiation is rarely reported. Thus, in this paper, a hybrid fabrication method of ZnO nanowires on laser created micro-bumps was proposed. The ZnO nanowires growth with time was investigated and a superhydrophobic, antibacterial surface was obtained.
2. Materials and Method
2.1. Sample Preparation
25 mm thick and 10 mm diameter samples of 304 stainless steel containing 18% chromium and 8% nickel were employed for the investigation. The samples were polished with 240 to 2000 grade sandpapers, and finally W5 diamond polishing lapping grind paste, to achieve a smooth surface. Then, the sample was cleaned in ethanol with an ultrasonic cleaner.
2.2. Laser Processing
A femtosecond laser (Legend Elite-1KHz, Coherent, Palo Alto, CA, USA) with pulse duration of 35 fs at a central wavelength of 800 nm was employed for the experiments. The laser processing was performed by a computer controlled XY translation stage. The repetition rate was fixed at 1 kHz. The hatching distance was 0.02 mm and scanning speed was 1 mm/s. Pulse distance was 1µm. The pulse energy was varied from 0.02 mJ to 0.5 mJ and the corresponding laser fluence was varied from 0.71–17.68 J/cm2. Laser beam focal spot size was around 60 μm. The corresponding information is shown in Table 1.

Table 1.
Laser processing parameters.
2.3. Surface Characterization
The sample surface morphology was observed with SEM (EM-20, COXEM, Daejeon, Korea). Surface chemical elements were examined with EDS. Water contact angle was measured with a contact angle measurement machine (SDC-350, Dongguan Precision Instrument, Dongguan, China) by a sessile drop method. Deionized water (DI water) was used for the measurement and the droplet size was 1µm. The roll-off angle was measured by rotating the sample stage and the angle was taken as the droplet starts to roll off the surface. The surface roughness was measured by a confocal microscopy (Olympus-Lext-OLS4000, Tokyo, Japan) at 50× magnification.
2.4. ZnO Nanowires Fabrication
To create micro/nano hierarchical surface structure, ZnO nanowires were fabricated on laser-treated 304 stainless steel surfaces. Laser power was 500 mW at a scanning speed of 0.2 mm/s. The hatching density was fixed at 0.04 mm. ZnO nanowires were fabricated with a hydrothermal synthesis method. Firstly, the pre-solution was prepared with 2.20 g zinc acetate, 20 mL methoxyethanol, and 0.61 mL ethanol amine, with magnetic stirring for 30 min. The mother liquor was prepared with 0.74 g zinc nitrate hexahydrate, 0.35 g methenamine, and 100 mL DI water, with magnetic stirring for 30 min. The polished 304 stainless steel sample was dipped into the pre-solution for few seconds, then moved out and heated in an oven for 5 min at a temperature of 350 °C, before it was cooled down to room temperature. The sample was then placed in polytetrafluoroethylene reaction still, and the mother liquor was slowly poured into the polytetrafluoroethylene reaction still. The growing liquid was then heated to 85 °C and maintained for 15 h. The sample was then removed from oven and cooled to room temperature for cleaning with DI water.
2.5. Antibacterial Test
A plate count method is applied for the antibacterial test. (1) The E. coli glycerol bacteria were inoculated in 10 mL Lysogeny broth (LB) medium at a concentration of 1:10 k, and cultured in a shaker at 37 °C for 16 h. (2) A 100 µL of the overnight culture media was resuspended in 10 mL LB media and incubated at 37 °C for 4 h. The cultured bacteria were used in the experiment with bacterial inoculation concentration of 105 CFU mL−1. (3) Inoculate 1 mL of bacterial solution with a concentration of 105 CFU mL−1 into a 12-well plate, place the prepared substrate in the plate, shake and mix well, and then place it in a 37 °C incubator for 6 h. (4) After 6 h of culture, the OD600 curve was measured by the microplate reader, and the number of bacteria was determined according to the standard curve. (5) All substrates were washed with PBS to remove unattached bacteria. (6) Rinse the surface of the substrate with LB medium to wash out the adherent bacteria, apply gradient dilution to 6 cm petri dishes, and invert overnight in a 37-degree incubator. (7) The antibacterial rate of the prepared surface against E. coli was measured by the plate count method.
3. Results and Discussion
3.1. Micro/Nano Hierarchical Structure Creation
Micro/nano hierarchical structures have a lot of advantages compared with single micro or nano structures. A mimic of lotus leaf micro/nano hierarchical structures on surfaces can enhance the material surface wettability. A superhydrophobic surface with self-cleaning function could be obtained. In this research, a hierarchical structure was created with a hybrid method. Firstly, microscale bumps were created with femtosecond laser irradiation as shown in Figure 1. The laser scanning speed was fixed at 1 mm/s with a hatching density of 0.02 mm. As depicted in Figure 1, at low laser fluence ranging from 0.71 J/cm2 to 10.61 J/cm2, 2D microgroove structures were observed on the surface. At a laser fluence of 7.07 J/cm2 and 10.61 J/cm2, a small number of micro-bumps was found on the edge of microgrooves. At a laser fluence of 12.38 J/cm2 and 14.15 J/cm2, massive micro-bumps were formed along the ablation line. When laser fluence further increased to 17.68 J/cm2, serious surface ablation occurred, and the micro-bump structure was destroyed. Thus, the micro-bump structure was only formed at a certain range of laser fluence, neither too low nor too high. For simple fabrication and energy saving, a laser fluence of 12.38 J/cm2 was chosen for micro bumps structure fabrication.

Figure 1.
Surface morphology of 304 stainless steel at different laser fluence: (a) 0.71 J/cm2, (b) 1.42 J/cm2, (c) 2.12 J/cm2, (d) 5.66 J/cm2, (e) 7.07 J/cm2, (f) 10.61 J/cm2, (g) 12.38 J/cm2, (h) 14.15 J/cm2, (i) 17.68 J/cm2. Laser scanning speed was fixed at 1 mm/s, the hatching density was set as 0.02 mm.
The laser beam was in Gaussian distribution. When laser fluence was higher than the ablation threshold, the material was ablated and followed by oxidation and ejection. At high laser fluence (such as 12.38 J/cm2 & 14.15 J/cm2), the material was melted in the center of laser irradiation zone. The generated high temperature gradient could induce radial surface tension gradient. Melted material could be expelled to the periphery of micro-melts and rapidly solidified result a rough surface. Particles in the micro-melts were ejected from the surface and yielded a recoil pressure that squirted the liquid metal outside the micro-melts. Thus, micro-bumps were formed along the micro-grooves [27].
ZnO nanowires were fabricated on a laser-created microstructure surface with a hydrothermal synthesis method as shown in Figure 2. The micro bumps were created at a laser fluence of 12.38 J/cm2. The ZnO nanowires growth with time was studied. It was found that after 9 h of growth, there are some ZnO nanowires formed on the material surface as shown in Figure 2a,b. After 12 h, the amount of ZnO nanowires increased dramatically. At 15 h, a huge cluster of ZnO nanowires was found on the surface. The surface element was measured as shown in Figure 3 and Table 2.

Figure 2.
ZnO nanowires growing on laser-created micro-structure surface at different time: (a,b) 9 h at magnification of 5000× and 10,000×, (c,d) 12 h at magnification of 5000× and 10,000×, (e,f) 15 h at magnification of 5000× and 10,000×.

Figure 3.
EDS measurement results of hierarchical structure surface. Red arrow indicates the micro bump base and the yellow arrow indicates the ZnO nanowire area.

Table 2.
Surface element of microstructure base and ZnO nanowires of hierarchical structure surface measured by EDS.
3.2. Surface Wettability
The surface wetting behavior of hierarchical structures were studied, as shown in Figure 4 and Table 3. The water contact angle of the original polished sample was around 76°. With micro-bumps created on the sample surface, the water contact angle was initially decreased to 15°. With ZnO nanowires fabricated on the surface, the surface water contact angle decreased to 40°. The surface water contact angle was 65° on the hierarchical micro/nano structured surface. After one month storage in ambient air environment, ageing occurred. The water contact angle of the structured surface increased to hydrophobic and even superhydrophobic. The water contact angles for the microstructured, nanostructured, and hierarchical structured surface were 137°, 115°, and 150°, respectively. It can be seen that the micro bumps surface had a higher water contact angle than the nanostructure surface. This was mainly due to the higher surface roughness of the micro bumps surface than the nanostructure surface. According to Wenzel’s model (refer to Equation (1)), the increased surface roughness can enhance the surface wettability. The ageing phenomenon is widely reported in literature [28,29]. The aging was mainly due to the increase of non-polar groups and decrease of oxygen polar groups on the surface [12,30]. The water contact angle increased significantly in the first few days, then the increasing rate slowed down; it took until one month for the water contact angle to achieve a relatively stable status [31]. Here, only the steady state water contact angle after ageing is examined.

Figure 4.
Surface water contact angle of (a) original polished 304 stainless steel, (b) micro-structured surface, (c) nano-structured surface, and (d) micro/nano hierarchical structure surface after one month storage in ambient air environment.

Table 3.
Surface water contact angle and roll-off angle of original and structured sample.
The roll-off angle of the original and structured surface was measured. The original and ZnO covered surface (ZnO nanowire surface and hierarchical surface) were quite sticky with a roll-off angle larger than 90°. For the laser-processed micro-bump surface, the roll-off angle is 17.6°. This was due to the polar property of ZnO as shown in Figure 3 the EDS-measured results. For the ZnO nanowire covered surface, the oxygen and zinc concentrations are much higher, as shown in Table 2. In order to achieve a superhydrophobic surface with low hysteresis, the sample was coated with trimethoxy silane. After coating, all the surfaces became more hydrophobic. The water contact angle of the original surface, micro-bump surface, ZnO nanowire surface, and hierarchical surface increased to 110°, 143°, 135°, and 152°, respectively. The original surface and ZnO nanowire surface were still sticky (roll-off angle > 90°), while the roll-off angle for the micro-bump surface and hierarchical surface was 8.13° and 7.3°, respectively.
There are two models generally applied to explain the surface wetting behavior: Wenzel’s model and the Cassie-Baxter model as shown in Figure 5. Wenzel’s model [32] is governed by:
where θw is the actual water contact angle, θf is the water contact angle of flat surface, and r is the roughness factor. We can see, for an initially hydrophilic surface, the presence of micro/nano structures will increase the value of , resulting in a smaller actual water contact angle. The water droplet can penetrate into the created micro/nano structures and the water contact angle is enhanced both ways with created surface structures as shown in Figure 5a. For an initially hydrophilic surface, the presence of micro/nano structures will increase the hydrophilicity, resulting in a smaller water contact angle. For original hydrophobic surfaces, the presence of micro/nano structures will result in a larger water contact angle; the surface becomes more hydrophobic. Thus, the surface structure could enhance surface wettability in both ways.

Figure 5.
Demonstration of (a) Wenzel’s model and (b) Cassie-Baxter model.
The Cassie-Baxter’s model [33] is governed by:
As micro/nano structure are created on the surface, air gas can be trapped in the gap between the micro/nano structures, thus resulting in a hydrophobic surface as shown in Figure 5b. The trapped air could prevent the water droplet penetrating into the material surface. This theory is usually used to explain superhydrophobic wetting behaviors, and generally with small sliding angle.
For uncoated surfaces, we can see the roll-off angle of the original sample surface and ZnO covered surface were larger than 90°. This was due to the penetration of water droplets into the material surface, which follows Wenzel’s theory, since ZnO has polar groups, which is water-loving. The presence of ZnO nanowires could easily puncture the water droplet surface, resulting in a sticky surface. In the case of micro-bump surfaces, the water droplet can slide down the surface with an angle of 17.6°. The presence of micro bumps on the surface could trap some air in between the microstructures. However, the hysteresis is still considerably higher. A transition state between Wenzel’s status and Cassie-Baxter status is presented. The surface roughness of the original surface and structured surface is measured as shown in Figure 6. The surface roughness for the original surface, micro-bump surface, ZnO nanowire surface, and hierarchical surface were 0.03 µm, 5.9 µm, 0.58 µm, and 6.67 µm, respectively. We can see, the static water contact angle was increased with surface roughness. It can be seen that the micro bumps surface had a higher water contact angle than the nanostructure surface. This was mainly due to the higher surface roughness of the micro bumps surface than the nanostructure surface. According to Wenzel’s model (refer to Equation (1)), the increased surface roughness can enhance the surface wettability. In the case of coated surfaces, the roll-off angle of the original and ZnO nanowires surface are larger than 90°. Low roll-off angle (<10°) was observed for the micro-bump surface and hierarchical surface. For the original surface and ZnO nanostructure surface, after coating, there was no air trapped in between the structures. It follows Wenzel’s model. For the micro-bump surface and hierarchical surface, the surface is much rougher. After coating, air can be trapped in between these micro or micro-nano structure surfaces. Thus, water droplets can easily slide down the surface.

Figure 6.
Surface roughness of original stainless steel surface and structured surface.
3.3. Antibacterial Property
For biomedical applications, the hydrophobic ZnO structured surface could help prevent bacterial contamination from water, which is important for implants. Moreover, ZnO material itself has good biocompatibility and antibacterial property. Thus, in this project, the antibacterial property is measured with a plate counting method. As shown in Figure 7, the optical density (OD) of E. coli attached to different structured surfaces is calculated. We can see that for the original surface, most bacteria were found to attach to the surface. The OD is measured to be 0.93. For the micro-structure surface (with bumps), the OD is 0.9 and for the hierarchical surface (with bump and nanowires), it is 0.54. For the nanostructured ZnO nanowire surface, the OD is only 0.09. It demonstrates good antibacterial properties of ZnO nanowires. The antibacterial property of ZnO nanowire surface is better than the hierarchical surface. This may be due to the decreased contact area of ZnO to bacteria, due to the bump structure. Thus, less bacteria are killed. There are several mechanisms could explain the antibacterial property of ZnO as reported in [17]. The reactive oxygen species could induct oxidative stress, thus leading to damage to cells and causing death. The release of Zn2+ could inhibit cell activity, including active transport, enzyme activity, etc. In addition, ZnO could attach to the cell surface through electrostatic force and subsequently cause distortion of membrane plasma structure and damage the cell integrity [17,34].
Figure 7.
Antibacterial property test: (a) bacterial growth and (b) optical density of bacteria on different structured sample surface.
4. Conclusions
In this work, we studied the wetting behavior of hierarchical structures. Superhydrophobic surfaces were obtained for micro-bump surface and hierarchical surface. A hydrophobic coating was applied to achieve a low hysteresis surface. The roll-off angle of the micro-bump surface and hierarchical surface after coating was 8.13° and 7.3°, respectively. For the uncoated surfaces, it follows Wenzel’s model. For coated surfaces, the original and ZnO nanowire surface follow Wenzel’s model, while the micro-bump and hierarchical surface follow the Cassie-Baxter model. This was due to the different surface roughness. For biomedical applications, the antibacterial property of the different scale structured surface was tested. The prepared surface structures could increase the antibacterial property. Moreover, the ZnO nanowires on the sample surface significantly influenced the antibacterial property. This work serves as a preliminary demonstration of the usage of femtosecond laser and a hydrothermal synthesis method for hierarchical structure fabrication. In future work, a simple and fast fabrication method can be developed. The effect of ZnO nucleation rate and thickness on surface wettability can be further studied.
Author Contributions
Conceptualization, B.W., H.S. and S.L.; validation, W.A., L.W. and H.Z.; investigation, B.W. and W.A.; writing—original draft preparation, B.W.; writing—review and editing, B.W., L.J., H.S. and S.L.; visualization, B.W., L.W. and W.A.; project administration, H.S. and S.L.; funding acquisition, H.S. and S.L. All authors have read and agreed to the published version of the manuscript.
Funding
This work is supported by the National Natural Science Foundation of China (Nos. 51875006 and 51705009), International Research Cooperation Seed Fund of Beijing University of Technology (No. 2021B21), Natural Science Foundation of Hebei Province (No. F2020208018) and Funding for Introduction of Overseas Researcher of Hebei Province (Project No. C20190331).
Conflicts of Interest
Authors state no conflict of interest.
References
- Sciancalepore, C.; Gemini, L.; Romoli, L.; Bondioli, F. Study of the wettability behavior of stainless steel surfaces after ultrafast laser texturing. Surf. Coat. Technol. 2018, 352, 370–377. [Google Scholar] [CrossRef]
- Zorba, V.; Stratakis, E.; Barberoglou, M.; Spanakis, E.; Tzanetakis, P.; Anastasiadis, S.H.; Fotakis, C. Biomimetic Artificial Surfaces Quantitatively Reproduce the Water Repellency of a Lotus Leaf. Adv. Mater. 2008, 20, 4049–4054. [Google Scholar] [CrossRef]
- He, H.; Guo, Z. Superhydrophobic materials used for anti-icing Theory, application, and development. iScience 2021, 24, 103357. [Google Scholar] [CrossRef] [PubMed]
- Bhushan, B.; Her, E.K. Fabrication of Superhydrophobic Surfaces with High and Low Adhesion Inspired from Rose Petal. Langmuir 2010, 26, 8207–8217. [Google Scholar] [CrossRef] [PubMed]
- Chen, Y.; Wang, H.; Yao, Q.; Fan, B.; Wang, C.; Xiong, Y.; Jin, C.; Sun, Q. Biomimetic taro leaf-like films decorated on wood surfaces using soft lithography for superparamagnetic and superhydrophobic performance. J. Mater. Sci. 2017, 52, 7428–7438. [Google Scholar] [CrossRef]
- Zheng, Y.; Gao, X.; Jiang, L. Directional adhesion of superhydrophobic butterfly wings. Soft Matter 2007, 3, 178–182. [Google Scholar] [CrossRef]
- Wang, S.; Yang, Z.; Gong, G.; Wang, J.; Wu, J.; Yang, S.; Jiang, L. Icephobicity of Penguins Spheniscus Humboldti and an Artificial Replica of Penguin Feather with Air-Infused Hierarchical Rough Structures. J. Phys. Chem. C 2016, 120, 15923–15929. [Google Scholar] [CrossRef]
- Silva, E.J.; Kirsch, B.; Bottene, A.C.; Simon, A.; Aurich, J.C.; Oliveira, J.F.G. Manufacturing of structured surfaces via grinding. J. Mater. Processing Technol. 2017, 243, 170–183. [Google Scholar] [CrossRef]
- Liu, L.H.; Michalak, D.J.; Chopra, T.P.; Pujari, S.P.; Cabrera, W.; Dick, D.; Veyan, J.F.; Hourani, R.; Halls, M.D.; Zuilhof, H.; et al. Surface etching, chemical modification and characterization of silicon nitride and silicon oxide--selective functionalization of Si3N4 and SiO2. J. Phys. Condens. Matter Inst. Phys. J. 2016, 28, 094014. [Google Scholar] [CrossRef]
- Colligon, J.S. Surface modification by ion beams. Vacuum 1986, 36, 413–418. [Google Scholar] [CrossRef]
- Stratakis, E.; Ranella, A.; Fotakis, C. Biomimetic micro/nanostructured functional surfaces for microfluidic and tissue engineering applications. Biomicrofluidics 2011, 5, 013411. [Google Scholar] [CrossRef] [PubMed]
- Gaddam, A.; Sharma, H.; Karkantonis, T.; Dimov, S. Anti-icing properties of femtosecond laser-induced nano and multiscale topographies. Appl. Surf. Sci. 2021, 552, 149443. [Google Scholar] [CrossRef]
- Wang, X.C.; Wang, B.; Xie, H.; Zheng, H.Y.; Lam, Y.C. Picosecond laser micro/nano surface texturing of nickel for superhydrophobicity. J. Phys. D: Appl. Phys. 2018, 51, 115305. [Google Scholar] [CrossRef]
- Žemaitis, A.; Mimidis, A.; Papadopoulos, A.; Gečys, P.; Račiukaitis, G.; Stratakis, E.; Gedvilas, M. Controlling the wettability of stainless steel from highly-hydrophilic to super-hydrophobic by femtosecond laser-induced ripples and nanospikes. RSC Adv. 2020, 10, 37956–37961. [Google Scholar] [CrossRef]
- Wang, B.; Wang, X.; Zheng, H.; Lam, Y. Femtosecond laser-induced surface wettability modification of polystyrene surface. Sci. China Phys. Mech. Astron. 2016, 59, 124211. [Google Scholar] [CrossRef]
- Pan, R.; Zhang, H.; Zhong, M. Triple-Scale Superhydrophobic Surface with Excellent Anti-Icing and Icephobic Performance via Ultrafast Laser Hybrid Fabrication. ACS Appl. Mater. Interfaces 2021, 13, 1743–1753. [Google Scholar] [CrossRef]
- Mardosaitė, R.; Jurkevičiūtė, A.; Račkauskas, S. Superhydrophobic ZnO Nanowires: Wettability Mechanisms and Functional Applications. Cryst. Growth Des. 2021, 21, 4765–4779. [Google Scholar] [CrossRef]
- Bhavsar, K.; Ross, D.; Prabhu, R.; Pollard, P. LED-controlled tuning of ZnO nanowires’ wettability for biosensing applications. Nano Rev. 2015, 6, 26711. [Google Scholar] [CrossRef]
- Mishra, Y.K.; Modi, G.; Cretu, V.; Postica, V.; Lupan, O.; Reimer, T.; Paulowicz, I.; Hrkac, V.; Benecke, W.; Kienle, L.; et al. Direct Growth of Freestanding ZnO Tetrapod Networks for Multifunctional Applications in Photocatalysis, UV Photodetection, and Gas Sensing. ACS Appl. Mater. Interfaces 2015, 7, 14303–14316. [Google Scholar] [CrossRef]
- Yong, J.; Chen, F.; Yang, Q.; Fang, Y.; Huo, J.; Hou, X. Femtosecond laser induced hierarchical ZnO superhydrophobic surfaces with switchable wettability. Chem. Commun. 2015, 51, 9813–9816. [Google Scholar] [CrossRef]
- Ghannam, H.; Chahboun, A.; Turmine, M. Wettability of zinc oxide nanorod surfaces. RSC Adv. 2019, 9, 38289–38297. [Google Scholar] [CrossRef] [PubMed]
- Huang, Y.; Sarkar, D.K.; Chen, X.G. Superhydrophobic nanostructured ZnO thin films on aluminum alloy substrates by electrophoretic deposition process. Appl. Surf. Sci. 2015, 327, 327–334. [Google Scholar] [CrossRef]
- Colon, G.; Ward, B.C.; Webster, T.J. Increased osteoblast and decreased Staphylococcus epidermidis functions on nanophase ZnO and TiO2. J. Biomed. Mater. Res. A 2006, 78, 595–604. [Google Scholar] [CrossRef] [PubMed]
- Sirelkhatim, A.; Mahmud, S.; Seeni, A.; Kaus, N.H.M.; Ann, L.C.; Bakhori, S.K.M.; Hasan, H.; Mohamad, D. Review on Zinc Oxide Nanoparticles: Antibacterial Activity and Toxicity Mechanism. Nanomicro Lett. 2015, 7, 219–242. [Google Scholar] [CrossRef]
- Abebe, B.; Zereffa, E.A.; Tadesse, A.; Murthy, H.C.A. A Review on Enhancing the Antibacterial Activity of ZnO: Mechanisms and Microscopic Investigation. Nanoscale Res. Lett. 2020, 15, 190. [Google Scholar] [CrossRef]
- Shaban, M.; Mohamed, F.; Abdallah, S. Production and Characterization of Superhydrophobic and Antibacterial Coated Fabrics Utilizing ZnO Nanocatalyst. Sci. Rep. 2018, 8, 3925. [Google Scholar] [CrossRef]
- Xing, W.; Li, Z.; Yang, H.; Li, X.; Wang, X.; Li, N. Anti-icing aluminum alloy surface with multi-level micro-nano textures constructed by picosecond laser. Mater. Des. 2019, 183, 108156. [Google Scholar] [CrossRef]
- Boinovich, L.B.; Emelyanenko, A.M.; Emelyanenko, K.A.; Domantovsky, A.G.; Shiryaev, A.A. Comment on “Nanosecond laser textured superhydrophobic metallic surfaces and their chemical sensing applications” by Duong V. Ta, Andrew Dunn, Thomas J. Wasley, Robert W. Kay, Jonathan Stringer, Patrick J. Smith, Colm Connaughton, Jonathan D. Shephard (Appl. Surf. Sci. 357 (2015) 248–254). Appl. Surf. Sci. 2016, 379, 111–113. [Google Scholar] [CrossRef]
- Trdan, U.; Hočevar, M.; Gregorčič, P. Transition from superhydrophilic to superhydrophobic state of laser textured stainless steel surface and its effect on corrosion resistance. Corros. Sci. 2017, 123, 21–26. [Google Scholar] [CrossRef]
- Wang, B.; Wang, X.; Zheng, H.; Lam, Y.C. Surface Wettability Modification of Cyclic Olefin Polymer by Direct Femtosecond Laser Irradiation. Nanomaterials 2015, 5, 1442–1453. [Google Scholar] [CrossRef]
- Wang, B. Surface Modification of Polystyrene by Femtosecond Laser Irradiation. J. Laser Micro/Nanoeng. 2016, 11, 253–256. [Google Scholar] [CrossRef]
- Wenzel, R.N. Resistance of solid surfaces to wetting by water. Ind. Eng. Chem. 1936, 28, 988–994. [Google Scholar] [CrossRef]
- Cassie, A.B.D.; Baxter, S. Wettability of porous surfaces. Trans. Faraday Soc. 1944, 40, 546–551. [Google Scholar] [CrossRef]
- Mohd Yusof, H.; Mohamad, R.; Zaidan, U.H.; Abdul Rahman, N.A. Microbial synthesis of zinc oxide nanoparticles and their potential application as an antimicrobial agent and a feed supplement in animal industry: A review. J Anim Sci Biotechnol 2019, 10, 57. [Google Scholar] [CrossRef] [PubMed]
Publisher’s Note: MDPI stays neutral with regard to jurisdictional claims in published maps and institutional affiliations. |
© 2022 by the authors. Licensee MDPI, Basel, Switzerland. This article is an open access article distributed under the terms and conditions of the Creative Commons Attribution (CC BY) license (https://creativecommons.org/licenses/by/4.0/).